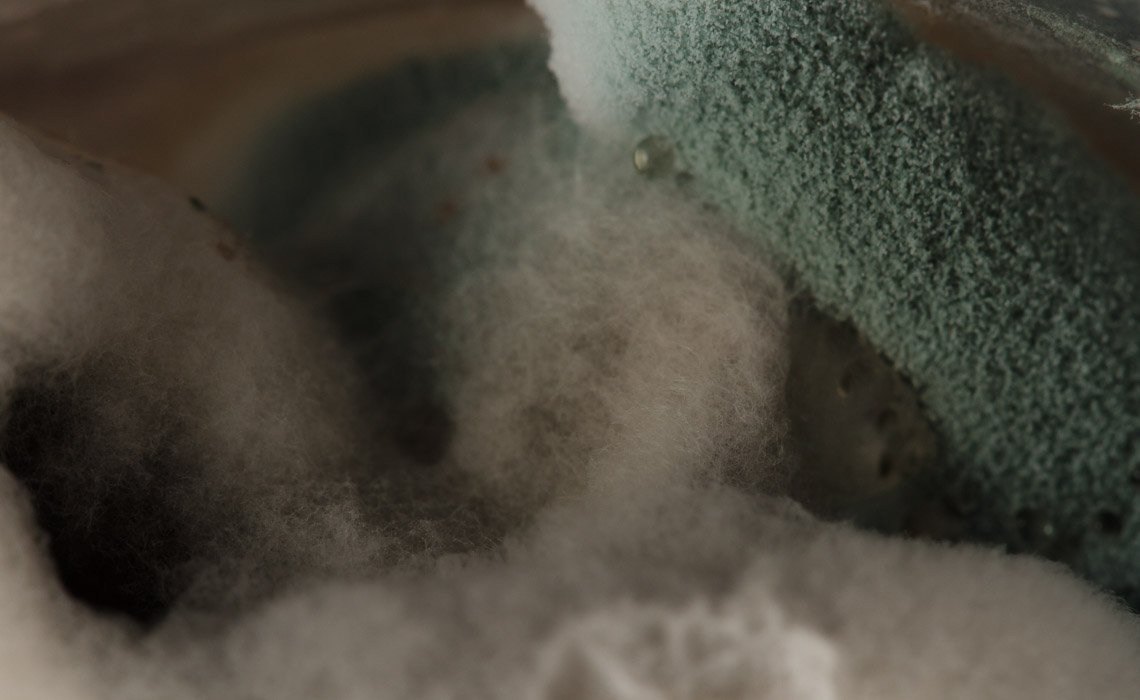
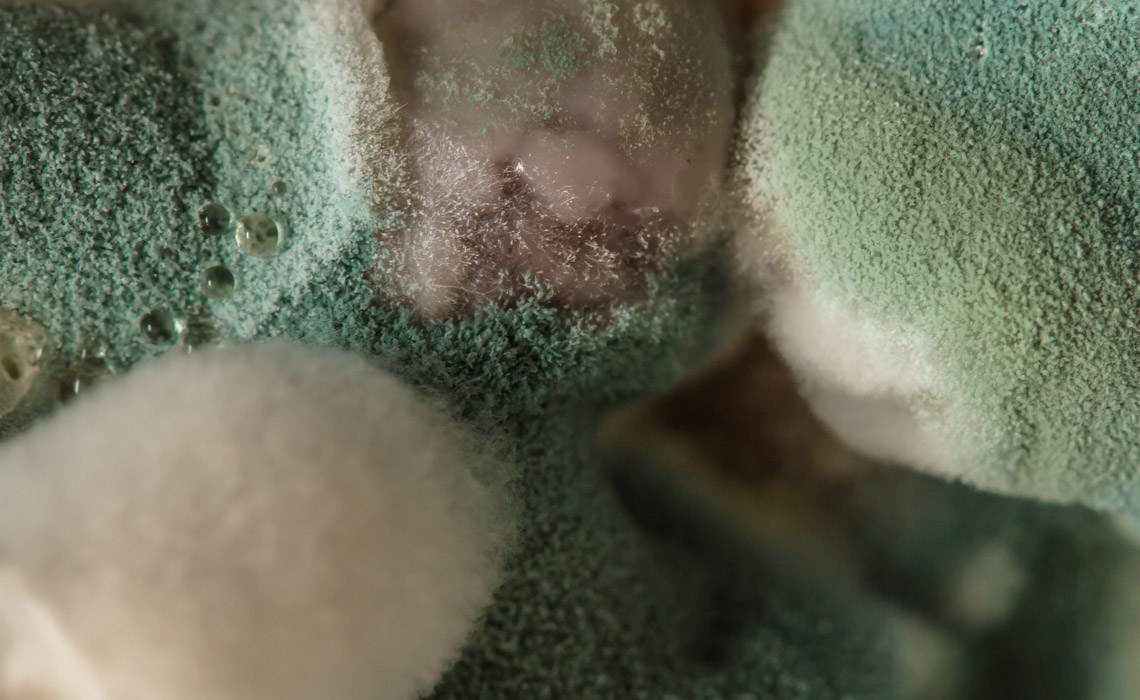
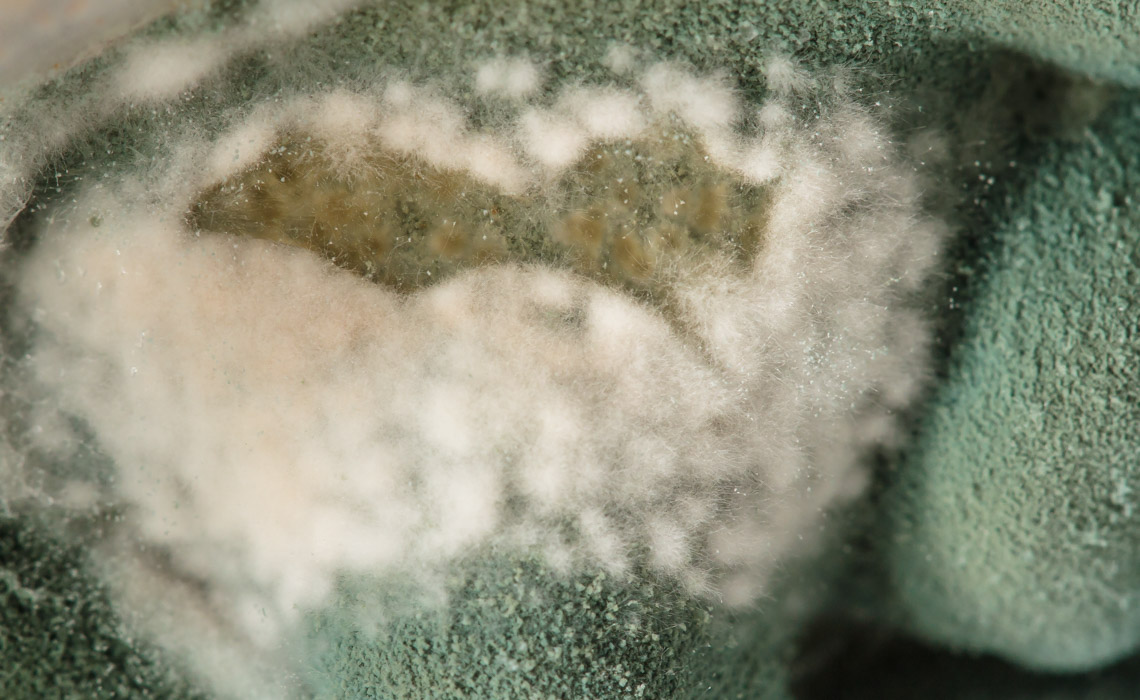
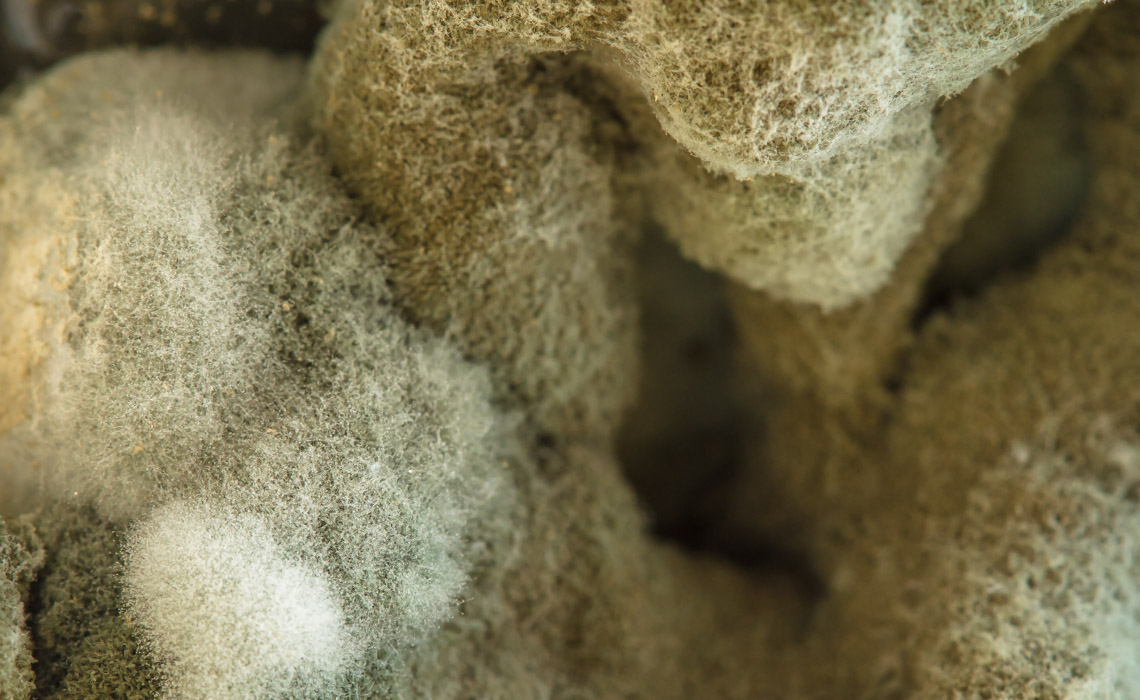

Alien Landscapes
| 14 imagesAlien landscapes. Or maybe Alien floralscapes? Alien to our sense of normalcy, for sure. No explanations this time. You’ve probably seen this before, it came from a cold place…you just never looked all that closely. 😉 You probably don’t really want to know what it is…but that doesn’t change the fact that it’s really interesting looking…

Was thinking part of fridge, but could be part of air handler of AC. Definite cool looking. When I was in high school I had a fascination with water molds. In humid dark places water grows interestingly cool stuff. I was also keen on unicellular critters in pond water.
Hmm, your very close with the fridge! Off on exactly what it is, though. 😉 I’ll see if anyone else can guess what it is.
I do agree, though, still or stagnant water can grow all sorts of interesting things!
Is it on coolant coils with condensation? Whatever it is I hope it is not INSIDE the fridge…with the FOOD…or even IS food!! My phycomycete project actually happened during a project about unicellular animals, but the water molds became much more prolific and interesting and hence the subject of the report. It was when I was in the Philippines.